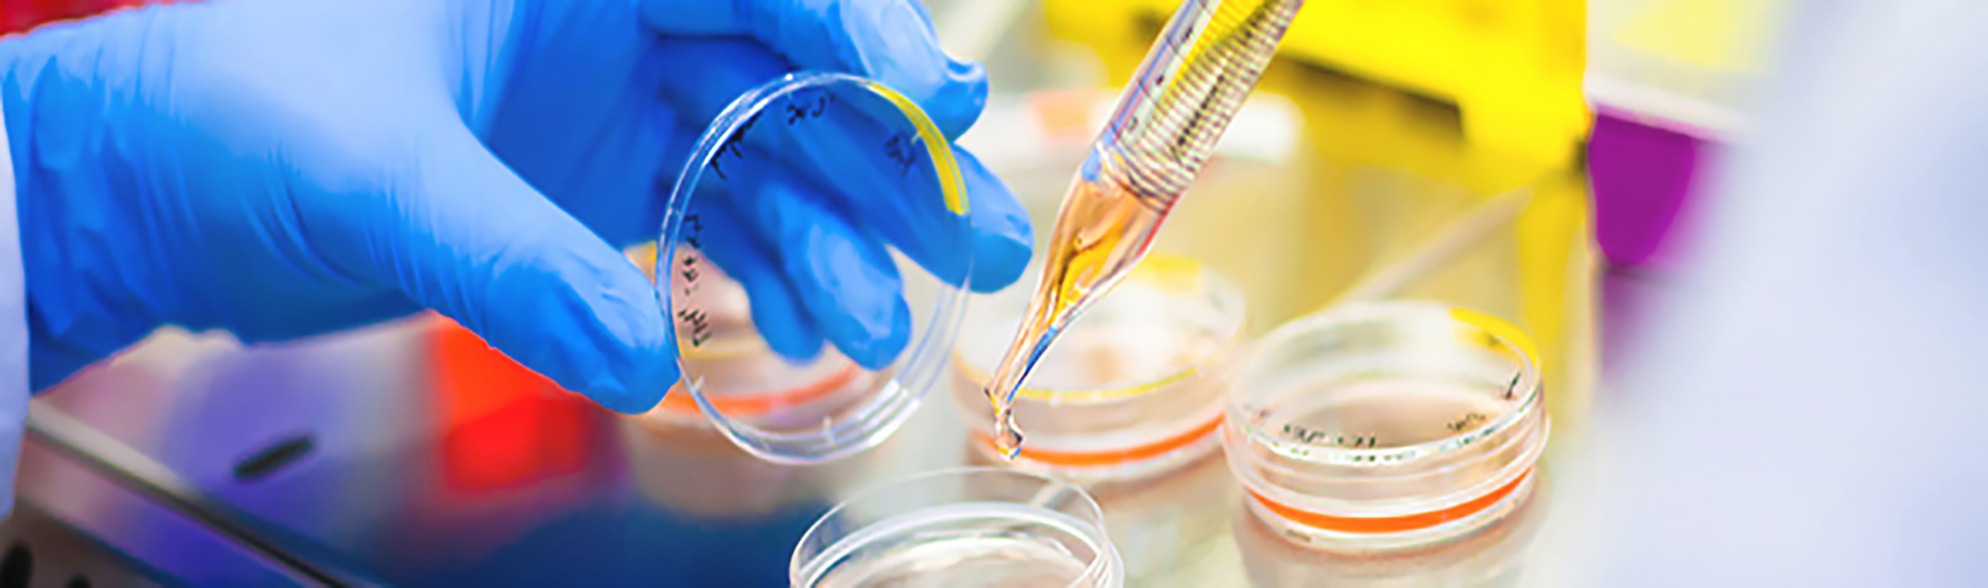

Cells Proliferation Control Medium
72hr change-free medium culture of human ES/iPS cells in Xyltech BOF-01
♠ BOF-01 is a novel basal culture medium which can suppress proliferation of human ES/iPS cell on feeder cell layers.
♠ BOF-01 can be used by completely replacing the basal culture medium (e.g. DMEM/F12) of the human ES/iPS cells.
♠ Human ES/iPS cells can be maintained with BOF-01 for about 3 days (up to 72 hours) with out changing medium under normal culture conditions (37ºC, 5% CO2).
♠ After suppression of cell proliferation with BOF-01, cell growth can be resumed by changing normal growth medium.
♠ This product does not contain glucose.
 Human Pluripotent Stem Cells Proliferation Control Medium_ Note
Human Pluripotent Stem Cells Proliferation Control Medium_ Note
Overview of Weekend-free Protocol
Morphology of Undifferentiated Cell Colony and Effect of Proliferation Control
Undifferentiation markers expression in Human iPS cells by BOF-01
 Maintained Human iPS Cells In Undifferentiated State.
Maintained Human iPS Cells In Undifferentiated State.
Differentiation of Three Germ Layers (Teratoma Assay)
 Maintained Human iPS cell In Pluripotent State
Maintained Human iPS cell In Pluripotent State
Colony Morphology changes during Proliferation Control Culture
 Colony Morphology changes during Proliferation Control Culture.
Colony Morphology changes during Proliferation Control Culture.